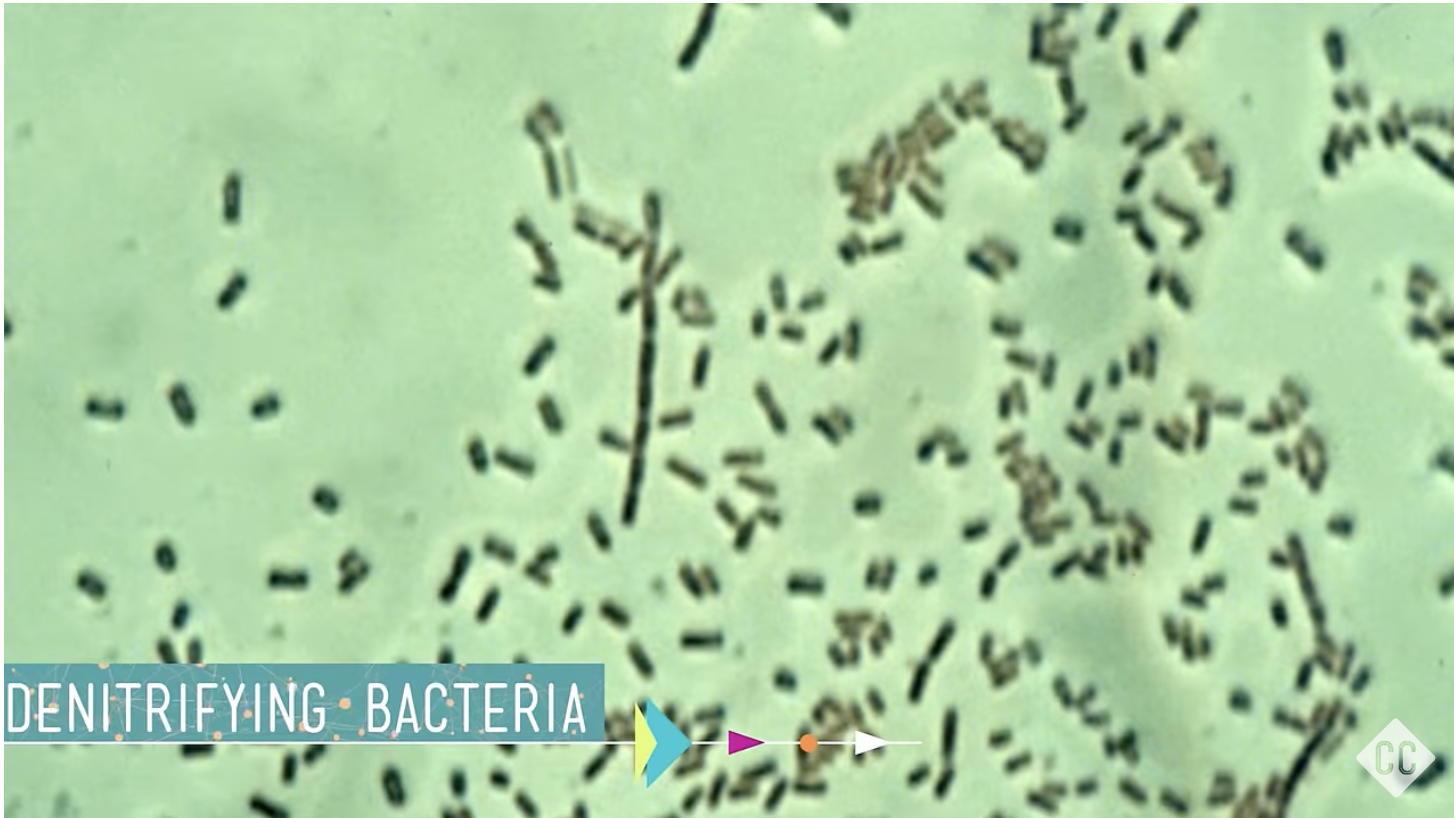

Similar Posts


Which Shrub?
To choose the best flowering shrub for your Black Hills yard, it’s all about matching the plant’s strengths with your gardening goals. Here is a comparison of the shrubs we currently offer, keeping local conditions and common uses in mind. Shrub Comparison for Black Hills Gardens Shrub Bloom Time Main Feature Best For… Why a…



Are My Mock Oranges… Mocking Me?
I love Mock Oranges. I love the smell… I love the color… just love em. However, they do their own thing, much like other plants in your landscape. I’ll try to remember to get video of the potted mock ranges in my nursery so you can see the differences.

The “Java Red” Mystery: Why This Red Shrub Is Actually… Pink?
If you’ve been scrolling through my 2026 catalog or visited the nursery last year, you might have noticed something a bit “wonky” about one of our favorite shrubs. It’s a question I get every single season: “If this is called ‘Java Red,’ why are the flowers so… pink?” It’s a fair question! In the world…
